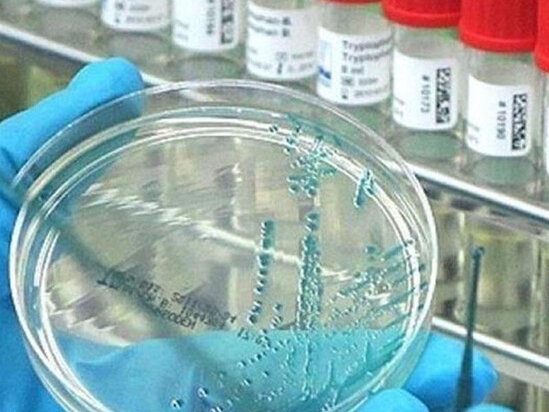
Araşdırma: Delta ştammı hər kəsi ovlayacaq!

Araşdırma: Delta ştammı hər kəsi ovlayacaq!
 Delta ştammı peyvənd olunmayan hər kəsi ovlayacaq.
Delta ştammı peyvənd olunmayan hər kəsi ovlayacaq.
Sonxeber.az axar.az-a istinadən xəbər verir ki, bu barədə İngiltərə alimlərinin apardığı araşdırmada bildirilib.
Alimlərin fikrincə, peyvənd olunmayan hər kəs bu ştamma yoluxacaq:
"BioTech peyvəndinin deltadan qoruma faizi 88-dir. Bu ştamm əvvəlkilərə nisbətdə daha yoluxucudur. Deltadan qorunmaq demək olar ki, mümkünsüzdür".
Sonxeber.az
 Telegramda izləyin
Telegramda izləyin
Sağlamlıq Baxılıb: 1917 Tarix: 20 sentyabr 2021
Şikayətiniz varsa Whatsapp: 077 7125666
Facebookda Paylaş
100 yaşa qədər yaşamağın sirri bu İMİŞ
Uzunömürlülüyü ilə tanınan İtaliyanın Sardiniya adasında sağlam həyatın sirri kimi qidalanma vərdişləri və güclü sosial əlaqələr göstərilir. xəbər verir ki, "Mavi Zona" kimi tanınan Sardiniyada yaşayan insanların əhəmiyyətli hissəsi 100 yaşdan çox ömür sürür. Mütəxəssislər bunu əsasən təz
2 iyunGündə neçə fincan çay içmək faydalıdır?
Çay ürək-damar xəstəlikləri və onkoloji xəstəliklər də daxil olmaqla, müxtəlif səbəblərdən ölüm riskinin azaldılmasına kömək edir. xəbər verir ki, bu barədə həkim-qastroenteroloq Darya Boqomolovanın açıqlamasına əsasən məlumat dərc edib. Yetkin insanlar üçün qara və ya yaşıl çayın tövsiyə olunan gündəli
14 iyun45 yaşdan sonra arıqlamaq niyə çətinləşir?
45 yaşdan sonra qadınların bədənində baş verən hormonal dəyişikliklər səbəbindən artıq çəki problemi daha çox müşahidə olunur. Mütəxəssislər bildirirlər ki, bu yaş dövründə bədənin dəyişməsi təbii prosesdir və əsas səbəb metabolizmin kəskin zəifləməsi deyil, hormonal balansın dəyişməsidir. Qaynarinf
3 iyunSubaylarda xərçəng riski daha yüksəkdir - Yeni ARAŞDIRMA
Yeni aparılan "Nikah və xərçəng riski" adlı genişmiqyaslı araşdırma göstərib ki, heç vaxt evli olmayan şəxslərdə əksər xərçəng növlərinə tutulma riski evli və ya əvvəllər evli olmuş insanlarla müqayisədə daha yüksəkdir. xarici KİV-ə istinadla bildirir ki, tədqiqat zamanı alimlər xərçəngə tutulm
21 iyunQəfil görünən damarlar hansı xəstəliklərin xəbərçisi ola bilər?
Əllərdə, ayaqlarda və ya sinə nahiyəsində damarların əvvəlkindən daha çox görünməyə başladığını hiss etmisiniz? Bir çox insan üçün bu, xüsusilə dəyişiklik qəfil olubsa, narahatlıq yaradır. xəbər verir ki, əksər hallarda nəzərəçarpan damarlar orqanizmin çəki dəyişikliyi, fiziki aktivlik, isti hava v
31 mayYayda bəzi ayaqqabıları geyinmək təhlükəlidir - Ortopeddən xəbərdarlıq
"Yay ayaqqabısının düzgün seçilməməsi sağlamlıq üçün mənfi nəticələrə yol aça bilər". xəbər verir ki, bunu -ya rusiyalı travmatoloq-ortoped Antonina Zavadskaya deyib. Həkimin sözlərinə görə, yay üçün ayaqqabı seçərkən ortopedik xəstəliklərdən və zədələnmə riskindən qorunmaq üçün onun konstruksiyasın
7 iyunKardioloqdan vacib xəbərdarlıq: Bu meyvə ürəyi qoruyur
Ürək sağlamlığını qorumaq istəyənlərə səhər yeməyində avokadodan istifadə etməyi məsləhət görüb. Onun sözlərinə görə, bu meyvə xolesterin səviyyəsinin azalmasına, qan təzyiqinin tənzimlənməsinə və ürək-damar sisteminin daha sağlam fəaliyyət göstərməsinə kömək edir. xəbər verir ki, mütəxəssis bildiri
7 iyun Delta ştammı peyvənd olunmayan hər kəsi ovlayacaq.
Delta ştammı peyvənd olunmayan hər kəsi ovlayacaq. Telegramda izləyin
Telegramda izləyin












 Soyuducuda xiyar saxlayarkən bu səhvi etməyin
Soyuducuda xiyar saxlayarkən bu səhvi etməyin Bakıda suyun kəsilməsi ilə bağlı RƏSMİ AÇIQLAMA
Bakıda suyun kəsilməsi ilə bağlı RƏSMİ AÇIQLAMA Universitetlər Bakıdan köçürülür? - Nazir AÇIQLADI
Universitetlər Bakıdan köçürülür? - Nazir AÇIQLADI Mürəbbə niyə günəş altında gözlədilir?
Mürəbbə niyə günəş altında gözlədilir? Təzəcə nişanlanmışdı: Faciəvi şəkildə həlak olan gənclə bağlı ÜRƏKDAĞLAYAN DETAL
Təzəcə nişanlanmışdı: Faciəvi şəkildə həlak olan gənclə bağlı ÜRƏKDAĞLAYAN DETAL Bakıda DƏHŞƏTLİ QƏZA: Avtobus yaşlı qadının üstündən keçdi - ANBAAN VİDEO
Bakıda DƏHŞƏTLİ QƏZA: Avtobus yaşlı qadının üstündən keçdi - ANBAAN VİDEO Şəhid ailələrinə yararsız qurban əti göndərən vəzifəli şəxsə töhmət verildi
Şəhid ailələrinə yararsız qurban əti göndərən vəzifəli şəxsə töhmət verildi Ayın 22-də ölkədə qısamüddətli yağış və külək gözlənilir - PROQNOZ
Ayın 22-də ölkədə qısamüddətli yağış və külək gözlənilir - PROQNOZ İnfarktdan sağ çıxan yüzlərlə şəxsin dedikləri diqqət çəkdi
İnfarktdan sağ çıxan yüzlərlə şəxsin dedikləri diqqət çəkdi Mərdəkanda dənizdə 4 nəfər batdı: Üçünün meyiti tapıldı
Mərdəkanda dənizdə 4 nəfər batdı: Üçünün meyiti tapıldı Azərbaycanda direktor müəllimlərin kartlarını mənimsədi: 71 min manatlıq yeyinti
Azərbaycanda direktor müəllimlərin kartlarını mənimsədi: 71 min manatlıq yeyinti Sevgilisini onun ən yaxın rəfiqəsi ilə aldatdı - FOTO
Sevgilisini onun ən yaxın rəfiqəsi ilə aldatdı - FOTO Səkkiz saat yatmaq həmişə faydalı deyil
Səkkiz saat yatmaq həmişə faydalı deyil Hüseyn Məhəmmədoğlu:"Get dişini düzəlt, pulun yoxdur?"
Hüseyn Məhəmmədoğlu:"Get dişini düzəlt, pulun yoxdur?" Orduda xidmət edən hərbçilərin saçları ilə bağlı mühüm qərar
Orduda xidmət edən hərbçilərin saçları ilə bağlı mühüm qərar